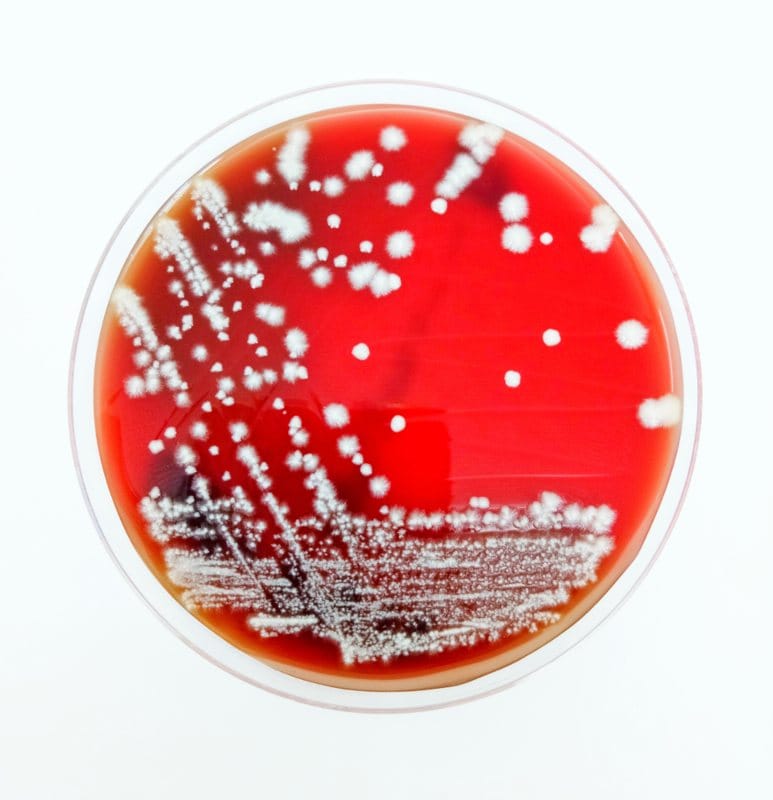
Kandida rast u laboratoriji u petri solji.

Kandida u usnoj duplji
- Sadržaj:
- 1. Stanja u kojima je kandida patogena
- 2. Simptomi oralne kandidijaze
- 3. Kako postaviti dijagnozu oralne kandidijaze?
- 4. Kako se leči kandida usne duplje?
- 5. Predložene preporuke
Sigurno ste nekada u svom životu primetili, a posebno u jutarnjim časovima, da je vaš jezik pobeleo, ili da je suv, ili da vas peče, ili da je malinast. Prvi dan obično niste obraćali pažnju na takvo stanje. Ali, ako vam se problem ponavljao svakodnevno, kod vas se javlja strah da nešto ipak nije u redu. Krećete u potragu – šta bi to moglo biti?
Prvo konsultujete ukućane, onda internet, a na kraju odlazite na pregled kod lekara koji vam postavlja dijagnozu – gljivica, odnosno kandida usne duplje. Međutim, tu vašim brigama nije kraj, jer ste na internetu mnogo toga pročitali što u vama izaziva strah o mogućim uzrocima pojave gljivice u ustima. Na internetu sam i ja pronašao razne podatke po kojima se kandida povezuje sa čitavim nizom bolesti kao što su – alergija na hranu, hronični umor, kožne promene, anksioznost, depresija, nesanica, gastralni refluks, HIV infekcije, sve do karcinoma… Kandida je česta i nakon primene antibiotika.
Kolika je prava istina u tome što nađemo na internetu, i da li imamo razloga za brigu?
U najvećem broju slučajeva nema razloga za brigu. Kandida je gljivica koja normalno živi u ustima, u ravnoteži s domaćinom, i ne uzrokuje nikakve probleme, pomaže u varenju hrane s drugim bakterijama usne duplje. Što se tiče bolesti koje su već spomenute, nema nikakvih dokaza o povezanosti bilo koje od navedenih bolesti s kandidom.
Kandida je mikroorganizam koji poput miliona drugih mikroorganizama živi na čoveku i unutar čoveka.
Međutim, postoje neka stanja kada kandida postaje patogena i izaziva infekciju usta.

Shutterstock.com
Stanja u kojima je kandida patogena
Oralna kandidijaza, gljivična infekcija usta uzrokovana kandidom, može se javiti kao posledica manjka pljuvačke i suvoće usta. Zatim, može nastati nakon primene antibiotika. Takođe, može se javiti kod nosioca proteza koje nisu stabilne i ne održavaju se na adekvatan način. Oralna kandidijaza može nastati i u mnogim sistemskim bolestima kao što su anemija i šećerna bolest. Isto tako, oralna kandidijaza može biti prvi znak težih poremećaja imunosistema, poput HIV-a, a može se javiti i kod pacijenata koji uzimaju imunosupresivne lekove, kao što su kortikosteroidi, imunosupresivi, hemoterapeutici. Može se javiti i nakon zračenja.
Jednom rečju, u svim stanjima u kojima se menja flora usne duplje i menja se acidobazni status u ustima.
Nakon porasta broja kandide, u ustima se javljaju i prvi simptomi. Simptomi se obično lagano povećavaju iz dana u dan.
Simptomi oralne kandidijaze
Oralna sluznica je ružičaste boje, a kod kandidijaze postaje žarkocrvene boje, a mogu biti vidljive i bele naslage koje se mogu skidati i sastrugati.
Simptomi gljivične infekcije su: pečenje, bol i neugodan ukus u ustima, suvoća i lepljivost usta.
Međutim, treba naglasiti da se ovakvi simptomi mogu videti i u drugim stanjima, ne samo kod oralne kandidijaze. Stoga je najbolje da dijagnozu postavi lekar specijalista. Dijagnozu nije teško postaviti, ukoliko je lekar već ranije video kako ona izgleda, a to je sigurno morao videti u toku svog usavršavanja.
Kako postaviti dijagnozu oralne kandidijaze?
Dijagnoza kandidijaze postavlja se kliničkim pregledom. Kandidijaza ima karakterističnu kliničku sliku koju specijalista otorinolaringologije može vrlo jednostavno prepoznati. Dijagnoza se potvrđuje nalazom mikološkog brisa grla, jezika i ponekad i ispljuvka. Treba istaći da nalaz mikološkog brisa može biti pozitivan i kod urednog kliničkog nalaza usne šupljine. U tom slučaju, ne radi se o infekciji nego o kolonizaciji kandidom, što je normalan nalaz. Drugim rečima, pozitivan nalaz brisa na kandidu, bez odgovarajuće kliničke slike, ne znači ništa. Nije razlog za zabrinutost, a još manje za lečenje. Kada smo je dijagnostikovali kliničkim pregledom i nalazom brisa, tada pristupamo lečenju.
Shutterstock.com
Kako se leči kandida usne duplje?
Kandidijaza se leči primenom protivgljivičnih lekova, takozvanih antimikotika. U većini slučajeva, primenjuju se lokalni preparati (daktanol, nistatin), dok se u težim slučajevima mogu ordinirati sistemski preparati (diflucan). Takođe, ako pacijenti nose proteze, potrebno je proveriti njihovu stabilnost i po potrebi ih podložiti, uveče držati u rastvoru sode bikarbone. Vrlo je važno naučiti pacijenta kako da održava dobru higijenu proteza. Uz lečenje infekcije, potrebno je isključiti i poremećaj koji je doveo do prelaska iz kolonizacije u infekciju, što uključuje merenje količine pljuvačke u ustima, pretrage krvi (krvna slika, šećer, gvožđe, vitamini B12 i folna kiselina), a u opravdanim slučajevima i testiranje na HIV infekciju.
Na kraju, treba da znamo šta je to što možemo samostalno da uradimo, i koje su to preporuke da se kandida ne pojavi u usnoj duplji?
Predložene preporuke
Održavajte oralnu higijenu, imajte uravnoteženu i zdravu ishranu, uzimajte dovoljno tečnosti i nemojte pušiti, izbegavajte kasne obroke, naročito slatkiše. Redovno posećujte stomatologa. Ukoliko imate povišenu kiselinu, redovno uzimajte terapiju. Jednom godišnje uradite kompletnu krvnu sliku s biohemijom i nalazima gvožđa, šećera, folne kiseline i vitamina B12.
I na kraju, treba znati da bez kandide čovek ne bi mogao da živi, ali nije dobro kada je ima previše. Uostalom, kao i svega u životu.
Naslovna fotografija – Shutterstock.com





